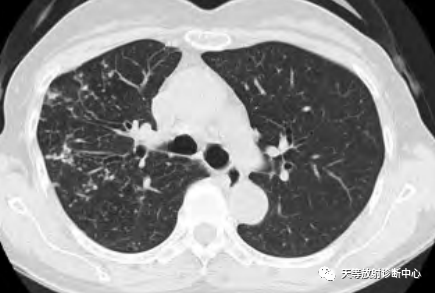

女性38岁。皮肤溃疡腹腔肿瘤术后2年。肿瘤是滤泡树突状细胞肉瘤。长期免疫抑制治疗。2018-2020年肺部提示隐球菌感染。治疗效果不佳。
患者多种疾病困扰,检验结果:单核细胞升高,白细胞不高,淋巴细胞比值降低,负向调节。
淋巴细胞百分率减低;
红系均明显降低(贫血?)
嗜酸性嗜碱性细胞正常。
糖类抗原升高。
真菌培养无生长。
先看看图像解析





影像学表现:整体观察肺内多发病灶,散在分布,病灶的主要形态为:多发大小不等肺气囊、多发结节共同存在。
1、肺气囊大小不等,张力较大,圆形膨胀感强,周围可见大小不等结节影;
2、病灶主要沿支气管血管束方向分布,部分病灶达到胸膜下;
3、支气管间质增厚;
4、结节影大小不等,小的呈树芽征堆积,大的部分到达胸膜小,具有糊墙征,性格较温和。仔细观察病灶呈四边形、多边形,边缘刀切感,边界模糊。
首先感觉病变并不是非常的恶,偏向温和的病变。
考虑:
1、LIP:通常和其他免疫性疾病有关,尤其是干燥综合征、自身免疫性甲状腺病、系统性红斑狼疮、以及HIV感染等。本病例免疫系统受到侵犯,免疫功能受到侵犯。影像学表现肺气囊+多发肉芽肿病变及间质增厚的表现,可以考虑。
2、淋巴瘤样肉芽肿病:发生于免疫功能减退人群的淋巴瘤样肉芽肿病,通常是一种EBV感染导致的淋巴增生性疾病。本病例长期使用免疫抑制治疗,病史非常符合。影像学多发结节影可以表现为支气管或血管周围的淋巴细胞浸润的病理,沿支气管血管来或胸膜下分布,还可见粗糙不规则密度增高影和薄壁小囊影。
3、隐球菌感染:多发肉芽肿的形态,边界模糊,征象还是有符合,隐球菌可以有空洞性 改变,本病例的囊主要是气囊的征象,不是空洞,因此考虑有点不搭调;
4、转移瘤。
综合考虑:LIP>淋巴瘤样肉芽肿病>隐球菌感染>转移瘤。
病理结果:NTM-鸟分支杆菌
每日记录
非结核分枝杆菌( NTM)
非结核分枝杆菌( NTM)是除结核分枝杆菌复合群和麻风分枝杆菌以外的一大类分枝杆菌的总称。NTM引起的肺部病变称为非结核分枝杆菌肺病 ( nontuberculous mycobacteria- pulmonary disease,NTM-PD)是分枝杆菌感染中的一个重要组成部分,NTM-PD的临床症状和影像学表现与肺结核极为相似,容易误诊而延误治疗。引起 NTM-PD 的常见菌种有胞内分枝杆菌、鸟分枝杆菌、脓肿分枝杆菌和堪萨斯分枝杆菌[1]
CT征象
NTM-PD感染较继发性肺结核双肺分布更为广泛,多累及右肺中叶和左肺上叶上舌段和下舌段,支气管扩张、薄壁空洞伴同侧肺叶肺段卫星病灶多提示 NTM感染[2-3]。
主要的征象包括:
小叶中心结节( 树芽征) 、肺小叶实变、肺段及肺大叶实变、空洞、支气管扩张、病灶内钙化灶、肺不张、肺气肿、肺大疱、肺损毁、纵隔肺门淋巴结肿大( 气管隆突下淋巴结直径≥1.5cm,其他纵隔内淋巴结直径≥1.0cm) 、淋巴结钙化、胸腔积液、胸膜增厚。
王安龙,司马斌,保春华.等[4]研究137例NTM-PD显示:
1、胞内分枝杆菌组、鸟分枝杆菌组、脓肿分枝杆菌与堪萨斯分枝杆菌组组间 CT 征象有重叠,肺小叶实变、肺段及肺大叶实变、肺不张、肺气肿、肺大疱、肺损毁、纵隔肺门淋巴结肿大、淋巴结钙化、胸腔积液等 CT 征象在 4 组之间差别无统计学意义。
2、肺小叶实变是4个菌种组中常见的CT征象,其病理多表现为淋巴细胞、巨噬细胞浸润和干酪样坏死为主的渗出性反应,干酪样坏死的程度和范围相对较低。3、非结核分枝杆菌毒力较弱,干酪性肺炎的段及肺大叶实变少见。
4、肺不张、肺气肿、肺大疱、肺损毁、纵隔肺门淋巴结肿大、淋巴结钙化、胸腔积液等CT征象在4个菌种组均少见。

▲胞内分枝杆菌肺病,左肺上叶空洞。

▲胞内分枝杆菌肺病,小叶中心结节(树芽征)

▲胞内分枝杆菌肺病,小叶中心结节(树芽征),双肺多发厚壁空洞。

▲胞内分枝杆菌肺病,右肺中叶支气管扩张,右肺下叶小叶中心结节
▲女,66 岁,鸟分枝 杆菌肺病,右肺上叶支气管扩张伴多发小叶中心结节(树芽征)

▲男,79 岁,脓肿分枝杆菌肺病,两肺多发支气管扩张伴小叶中心结节( 树芽征)

▲男,50 岁,堪萨斯分枝杆菌肺病,右肺上叶薄壁空洞。

▲堪萨斯分枝杆菌肺病,散在多发小叶中心结节,树芽征。(病例来源肺盟)

▲红星影像病例,非结核分支杆菌肺病(龟-脓肿复合群分支杆菌)。
各种征象出现率的对比:
1、小叶中心结节( 树芽征) :在胞内分枝杆菌组中最常见,其次为鸟分枝杆菌组及脓肿分枝杆菌组,在堪萨斯分枝杆菌组中出现最少。小叶中心结节(树芽征)的形成是由细支气管腔内存在坏死组织及(或)小叶内散在肉芽肿所致,同时反映了支气管及支气管周围炎症。
2、胞内分枝杆菌组中,支气管扩张CT征象的发生率仅次于小叶中心结节。鸟分枝杆菌组及脓肿分枝杆菌组中支气管扩张出现的比例差异无统计学意义。堪萨斯分枝杆菌组出现支气管扩张最少。
3、空洞是4个菌种组中常见的CT征象,空洞是由支气管壁及周围炎症形成结节,管壁溃疡坏死后,坏死物经支气管排出后形成。堪萨斯分枝杆菌组出现空洞的比 例要明显高于其他3组,而且空洞更多见于右肺上叶。不同菌种组中空洞的好发部位有其特征性,空洞的发生部位对判断各菌种有一定意义。

▲NTM的厚壁空洞
小结
胞内分枝杆菌肺病双肺常同时出现多种CT征象,且病灶多呈广泛分布;堪萨斯分枝杆菌肺病肺内出现的CT征象相对较单一,空洞常出现在右肺上叶是其特征性表现;鸟分枝杆菌肺病与脓肿分枝杆菌肺病的CT征象及病灶范围介于前两者之间。
参考文献:
[1]刘文斌. 社区老年人高血压流行病学调查[J].中国全科医学, 2011,14( 3) : 300-302.
[2]陈露,史河水,曲世林,等.非结核分枝杆菌肺病的 MSCT 表现 [J].放射学实践,2018,28( 2) : 161-165.
[3]姚景江,贺亚琼,张亚林.非结核分枝杆菌肺病的临床与 MSCT 表 现[J].中国医学影像技术,2017,33( 3) : 414-418.
[4]王安龙,司马斌,保春华.等.常见非结核分枝杆菌肺病的 MSCT 表现[J].健 康 研 究,2020,40(4):431-438.
 纵隔大细胞神经内分泌癌1例CT影像
纵隔大细胞神经内分泌癌1例CT影像  张力性纵隔气肿影像表现及严重度分级
张力性纵隔气肿影像表现及严重度分级  迅速增大的肺部结节,首先考虑良性,确诊需要肺穿
迅速增大的肺部结节,首先考虑良性,确诊需要肺穿  肺隔离症:易误诊为肺癌的占位性病变,肺穿刺禁忌!
肺隔离症:易误诊为肺癌的占位性病变,肺穿刺禁忌!  肺段与肺内管道应用解剖
肺段与肺内管道应用解剖  肺转移瘤的十种不典型CT表现
肺转移瘤的十种不典型CT表现  肺内淋巴结的CT表现特点及与病理对照
肺内淋巴结的CT表现特点及与病理对照  肺实变与肺不张的CT鉴别诊断
肺实变与肺不张的CT鉴别诊断  医生现身说法,这五种忙帮不得!
医生现身说法,这五种忙帮不得!  北大教授:要真正让医务人员有阳光体面的收入!医
北大教授:要真正让医务人员有阳光体面的收入!医  为值夜班的医生护士鼓与呼:请给我们更多关注!
为值夜班的医生护士鼓与呼:请给我们更多关注!  广东拟取消医院用药数量限制,满足患者多样性需求
广东拟取消医院用药数量限制,满足患者多样性需求  博士、硕士入职就给精装房!又有医院不惜下血本招
博士、硕士入职就给精装房!又有医院不惜下血本招  历时7年之久,温医生宣判无罪!
历时7年之久,温医生宣判无罪!  重磅!四川发文:严禁限制医生多点执业
重磅!四川发文:严禁限制医生多点执业  与真人医生诊断一致性达96%:AI医生应用前景广阔
与真人医生诊断一致性达96%:AI医生应用前景广阔 



